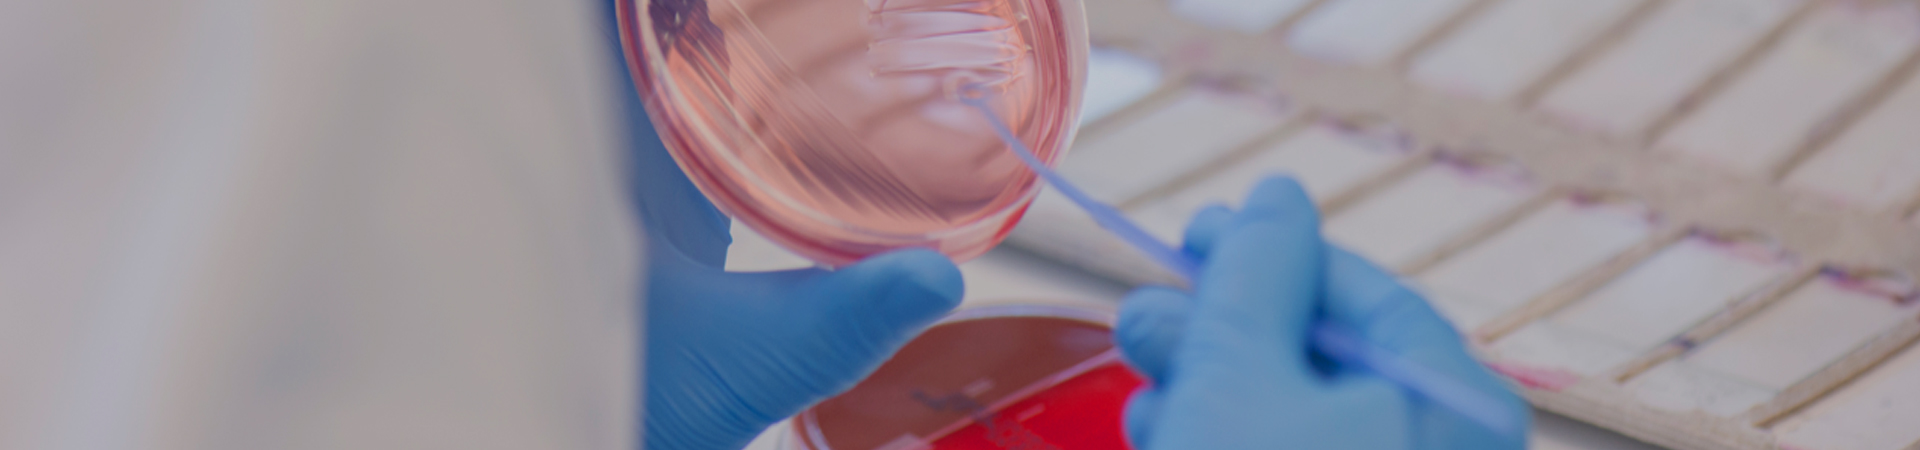

-
Research Milling & Pulverizing
- Enhanced multi-sample tissue grinder
- Enhanced automatic sample rapid grinder
- Enhanced cryomill
- Multi-sample tissue grinding machine
- Automatic sample rapid grinder
- Cryogenic tissue grinder
- Three-dimensional motion grinder
- Vacuum Cryo-Grinder
- Freezer tissue grinder
- Liquid nitrogen Cryogenic Grinder
- High Throughput Tissue Grinder
- Tissue Grinder
-
Analytical Milling & Pulverizing
- Hair drug detector
- Handheld Grinder
- QuEChERS pre-processing all-in-one machine
- Soil/High Energy Planetary Grinder
- Hammer cyclone mill
- Knife grinder
- Multifunctional/Automatic Homogenizer
- Three dimensional vibrating ball mill
- Chlorophyll/soil A grinder
- Mortar grinder
- High-efficiency vibrating disc grinder
- Jaw grinder
- Flap homogenizer
- Bead-milling tissue grinder
- Special grinder for African swine fever
- Three-dimensional mixing instrument
- Miniature bead mill
- Forensic bone and tooth ball mill
- Percussion grinder
- Rotary splitter
- Scientist Series
-
PrecisionLab Series
- Ultrasonic cell disruptor
- Ultrasonic equipment
- In situ hybridization instrument/n instrument/crosslinking
- instrument Dry type thermostat/constant temperature mixer
- Vortex mixer/nitrogen purging instrument
- PCR instrument/membrane sealing instrument Snow ice
- Microplate constant temperature shaking incubator
- Orbital shaker/micro centrifuge
- Inoculation loop sterilization/indicator incubator
- Solid phase extraction device/low temperature thermostat
- Snow ice maker/viscometer/lyophilizer
- Flip oscillator
- Soil drying box/humidity box
-
Xiao Mei Ultrasonic Series
-
Vibratory Sievers
- Imported Brands
Analytical Milling & Pulverizing